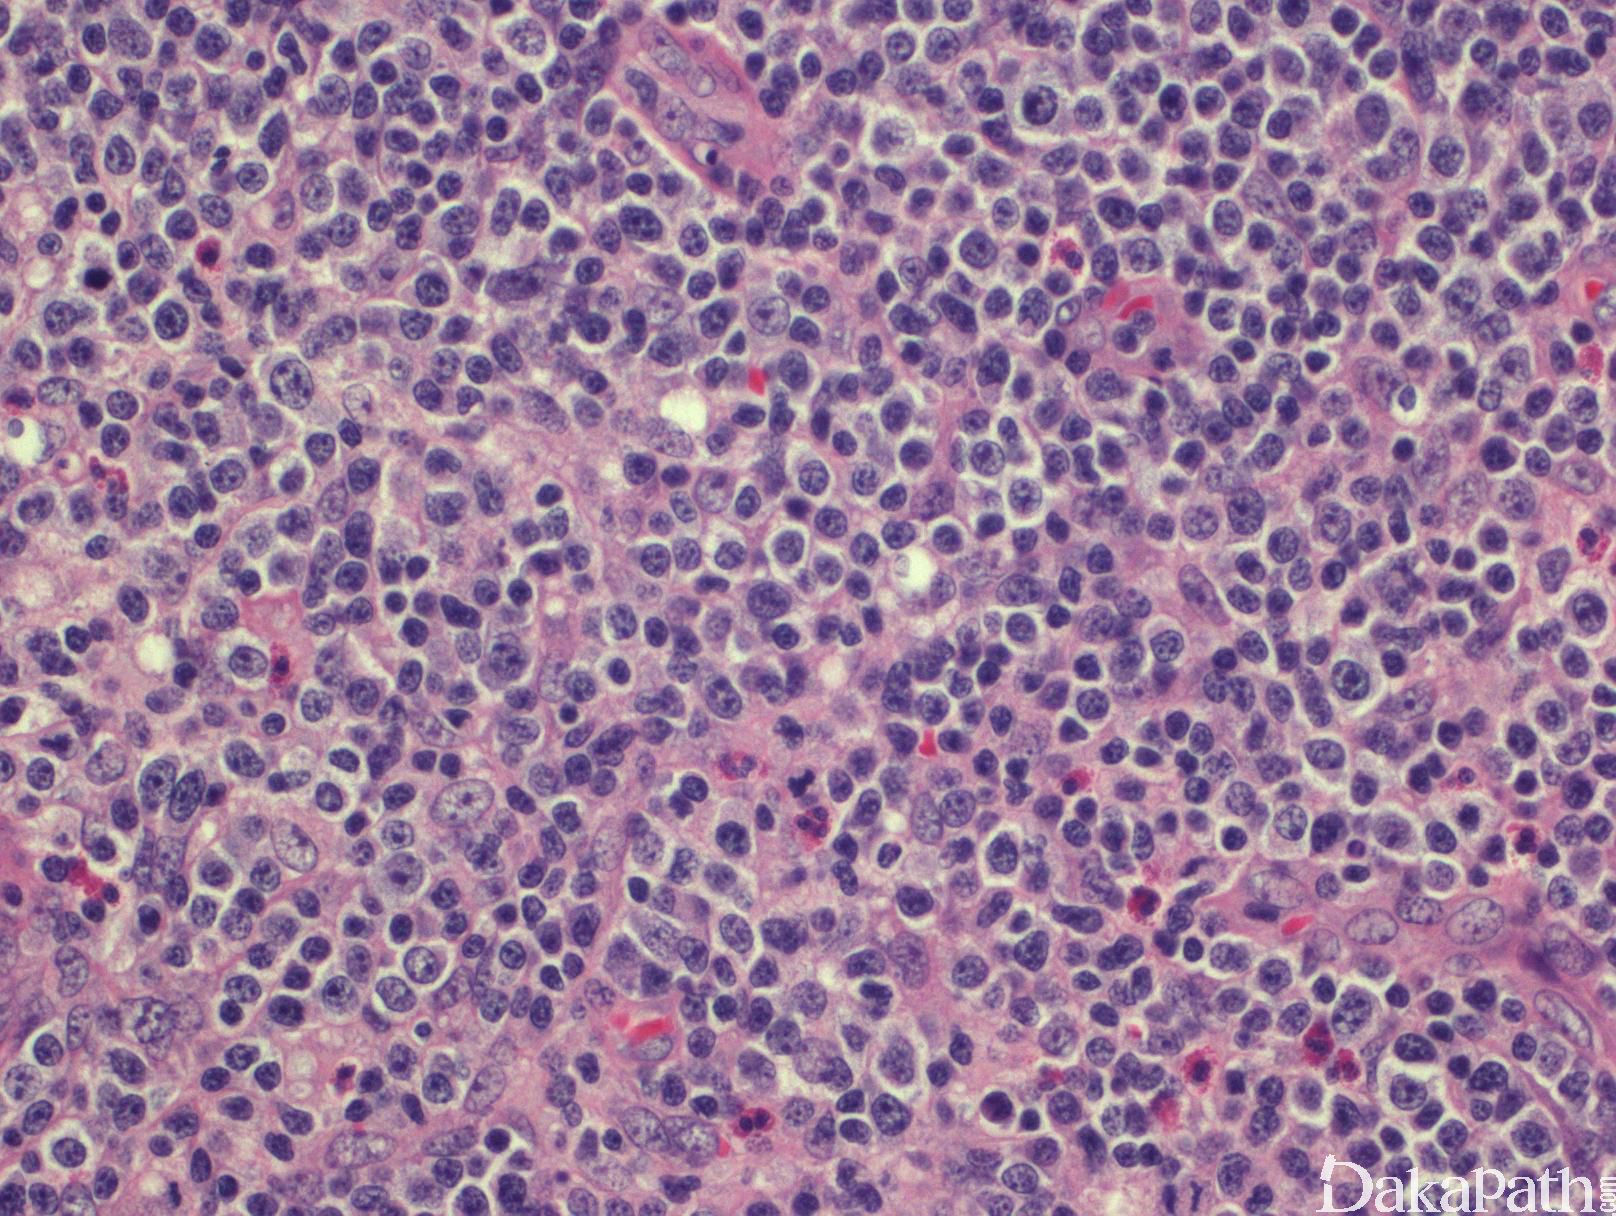

外周 T 细胞淋巴瘤,非特指型
Peripheral T-Cell Lymphoma, NOS
概述:
PCTL-NOS 是一类淋巴结或结外成熟 T 细胞肿瘤,缺乏足以进一步分类的特征性,目前不能归类为任一种已知的成熟 T 细胞肿瘤亚型。临床表现为侵袭性。
诊断要点:
- 见于中老年,偶有儿童发病。主要累及淋巴结(多发),也常累及结外组织包括皮肤、肝、脾和骨髓。临床表现为进展性,常有 B 症状。
- 淋巴结正常结构消失,代之以弥漫肿瘤增生,有时增生以副皮质区为主。背景血管增多,主要是高内皮小静脉,分枝丰富。皮肤常侵犯真皮和皮下,呈弥漫侵润或形成结节。骨髓为间质弥漫或局灶浸润。
- 肿瘤细胞小到中等,但也可以是大细胞,以病例而定。多数为中等大小,胞核不规则,核仁易见,核分裂频繁,胞质少到中等,有的表现为透亮胞质。有时可见 HRS 样细胞。背景通常混有很多反应性小淋巴细胞、嗜酸性细胞、组织细胞和浆细胞。
- 免疫表型:肿瘤细胞表达全 T 细胞抗原(CD3. CD2. CD5. CD7),缺失或弱表达其中一个或多个抗原常见。多数病例 CD4+、CD8-,少数 CD4-、CD8+,也有极少数为双阳性或双阴性。绝大多数病例为 TCRαβ 型(TCRβF1+) ,极少数 γδ 型(TCRβF1-)。散在大细胞可表达 CD30 ,但 CD15 阴性。也有报道 CD20 在肿瘤细胞有共表达,但绝大多数情况 CD20 显示的是反应性 B 细胞。偶尔见 B 细胞增生,但形成 B 细胞肿瘤少见。少数病例有散在 EBER +细胞(B 细胞)。
- TCR 基因克隆性重排。细胞遗传学常见复杂核型。表达 TBX21(TBT1)和 GATA3 具有特征性。
变异型:
淋巴上皮样变异型 :表现为大量的反应性上皮样组织细胞散在浸润,常形成小簇状,甚至掩盖了肿瘤细胞。大多为单核组织细胞,但多核也偶尔可见。肿瘤细胞常为小的非典型 T 细胞,有轻度核不规则或含透明胞质。可以是弥漫性浸润,也可以是滤泡间区生长。背景其它炎性细胞常见。
T 区变异型 :淋巴结基本结构保留伴反应性滤泡,肿瘤增生主要累及滤泡旁和滤泡间。肿瘤细胞小到中等,背景可有反应性炎性细胞。诊断具有挑战性,克隆性 TCR 基因重排和抗原丢失有助于明确诊断。此型在 WHO2017 版中不在认为是 PTCL-NOS 的变异型,而是一种非特异性的肿瘤生长模式,滤泡旁的肿瘤 T 细胞常呈现滤泡辅助细胞表型。
滤泡变异型 :肿瘤生长选择性累及滤泡,细胞形态多样,可由中等大小、具有透亮胞质的细胞组成,也可由类似于中心细胞和中心母细胞的细胞构成。细胞表达 CD3 和 CD4,也可表达 CD10,BCl-6 和 PD1。此型在 WHO2017 版中不在认为是 PTCL-NOS 的变异型,而属于 AITL 和其它结性滤泡辅助 T 细胞淋巴瘤。
原发性结性 EBV 阳性 NK 或 T 细胞淋巴瘤: 有报道。目前暂归属 PTCL-NOS 的变异型。原发于结内的肿瘤细胞呈现单形性弥漫生长,无血管破坏和坏死。

鉴别诊断:
- 血管免疫母 T 细胞淋巴瘤 (AITL):多为晚期,伴高丙种球蛋白血症。肿瘤弥漫增生,有多形态细胞组成(小、中、大细胞),含透明胞质的肿瘤细胞有时松散聚集。血管(高内皮静脉)增生更加显著,大量分枝。背景混有反应性炎性细胞。肿瘤细胞 CD3+、CD4+、CD10+、Bcl-6+、PD1+,CD23 和 CD21 显示扩张增生的滤泡树突状细胞网状结构,与增生的高内皮静脉相关。多数病例可见很多散在 EBER+细胞。
- 间变性大细胞淋巴瘤 (ALCL):少数 PTCL-NOS 病例有较多大细胞,CD30 阳性,易与 ALCL 混淆。标志性细胞、CD30 一致强阳性、EMA+、细胞毒表型、无 CD3 等 T 细胞相关抗原表达,EBER- 等支持诊断 ALCL。
- 经典型霍奇金淋巴瘤(CHL) :PTCL-NOS 有时伴 HRS 样细胞,EBER+,CD30+,CD15-/+,需与 CHL 相鉴别。PCTL 的 HRS 样细胞为反应性 B 细胞,背景 T 细胞为具异形性的肿瘤细胞,有克隆性 TCR 基因重排,免疫表型也可能异常。而 CHL 的背景细胞为反应性 T 细胞,免疫表型正常,无克隆性 TCR 基因重排。临床和影像学表现也有助于鉴别。
- 反应性淋巴组织增生/肉芽肿样淋巴结病变 :局限于副皮质区的反应性 T 细胞增生需与 T 区变异型相鉴别,而反应性肉芽肿样淋巴结病变则需与淋巴上皮样变异型相鉴别。 细胞的异形性、浸润性生长方式、结外侵犯、免疫表型、克隆性 TCR 基因重排及临床表现有助于诊断。
预后:
高度侵袭性,预后不良。骨髓累及、高增值指数(70%)、EBV+、CD30+
